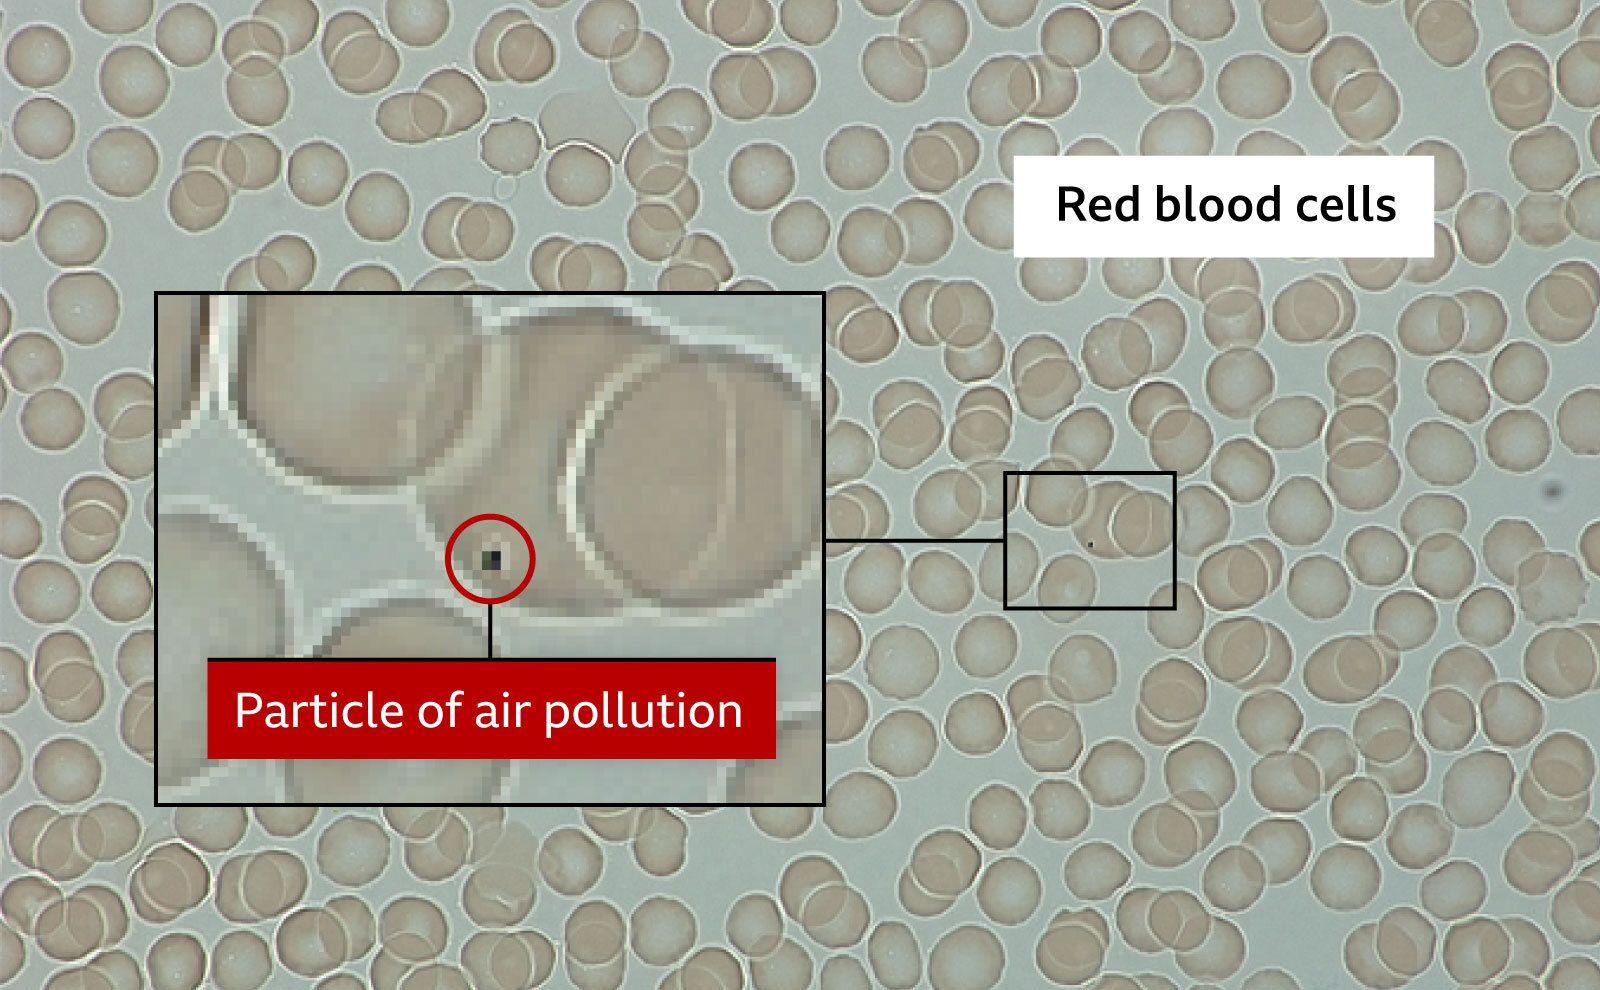
grafika krvnih zrnaca i čestica zagađenja

Udisao izduvne gasove da sazna šta zagađenje radi njegovom telu

Osećam se kontaminirano.
U laboratoriji sam i gledam u vlastitu krv pod mikroskopom.
Umesto besprekornih crvenih krvnih zrnaca, neka od njih su zaprljana crnim mrljama.
Sada sam jedan od prvih ljudi na svetu koji je uspeo da vidi kako se zagađenje vazduha taloži u njegovom telu.
Pre manje od sat vremena, stajao sam kraj četiri trake prometne centralne londonske saobraćajnice.
Bio je to onaj tip puta na kom možete da okusite vazduh i ostaje vam zrnast osećaj u ustima.
Dobrovoljno sam pristao da stojim tamo 10 minuta; udišući nečisti vazduh u sklopu eksperimenta za bolje razumevanje kako tačno zagađenje vazduha utiče na naša tela i škodi našem zdravlju.
U Velikoj Britaniji, veruje se da loš kvalitet vazduha ubije 30.000 ljudi godišnje, kao i da naškodi bebama u materici i pogoršava razna stanja, od astme do demencije.
Većina zagađenog vazduha koji sam udisao poticalo je od saobraćaja – dok se dimi nevidljivo iz auspuha, ali i ispušta od trošenja guma i kočnica.
Profesor Džonatan Grig, sa Univerziteta kraljica Meri u Londonu, naziva ovo mesto „komorom izlaganja“.
Vičući da nadglasa buku turiranja motora i automobilskih sirena, on mi kaže da većina ljudi pogrešno pretpostavlja da se zagađeni vazduh filtrira kroz naš nos i usta, ili da bude zatočen a potom da izlazi iz naših pluća.
„Ono što tražimo da vidimo je da li najmanje čestice ne samo ostaju u našim plućima, već prelaze u naš krvotok i kreću se po našem telu“, kaže Grig.

Nakon naše doze londonskog vazduha, vraćamo se u laboratoriju gde mi bodu prst i uzimaju mi uzorak krvi spreman za analizu.
Pod mikroskopom, lako možemo da vidimo crvena krvna zrnca u obliku diska koja prenose kiseonik svud po našem telu.
Potrebno mi je nekoliko minuta da mi se oči naviknu, ali onda zagađenje vazduha postaje očigledno.
Ono se javlja u obliku malih crnih tačaka zalepljenih za crvena krvna zrnca.
To su parčići ugljenika i drugih hemikalija, kao što su minijaturni komadi uglja, koji potiču od nekompletnog sagorevanja goriva.
Poznati su i kao PM 2.5, zato što su to čestice koje su manje od 2,5 mikrometara.
Nisam iznenađen što vidim zagađenje vazduha, zbog toga i radimo ovaj eksperiment, ali ne mogu da se ne osećam zaprljano, kontaminirano... ukaljano svime.
- Zagađenje vazduha u Srbiji i na Balkanu: Sve što treba da znate
- Kako da se izborite sa zagađenjem vazduha
- Zagađenje vazduha u Valjevu: Udah 'opasan po zdravlje'



Istraživačica doktorka Noris Liu je proučila krvne uzorke više od desetine volontera u sklopu studije.
U proseku, jedno na svake dve do tri hiljade crvenih krvnih zrnaca pokupilo je autostoperski komad zagađenja.
To možda ne zvuči kao mnogo, ali ako to prenesete na punih pet litara krvi kod odrasle osobe, istraživači procenjuju da bi moglo biti i 80 miliona crvenih krvnih zrnaca koje prenosi zagađenje po našim telima.
„Pomalo je iznenađujuće kad to vidite, zar ne?“, kaže Liu.
„Svaki put kad prođem pored prometnog puta, sada razmišljam o tome koliko toga putuje po mom telu... Odjednom vam se više ne ostaje dugo na putevima.“
Stajao sam pored puta svega 10 minuta.
Jeste bilo prometno, ali nije se radilo o ekstremnom scenariju.
I vaša krv verovatno izgleda isto tako.
Tim sa Univerziteta kraljica Meri u Londonu pokazao je da nivoi zagađenja vazduha u krvi opadnu posle oko dva sata udisanja svežeg vazduha.
Grig je bio „prilično šokiran“ što je zagađenje vazduha toliko vidljivo u krvi, ali kaže da je najvažnije pitanje gde ono posle odlazi.
Ono se ne izdiše nazad napolje, kaže on, njegov jedan deo možda filtriraju bubrezi i napuste telo u urinu.
Ali najverovatniji odgovor je da se čestice zagađenja „probiju kroz sluznice krvnih sudova i ukopaju se u raznim organima“.

Ovo istraživanje počinje da objašnjava zašto je zagađenje vazduha povezano sa toliko mnogo zdravstvenih problema izvan kategorije pluća, među kojima su mozak i bebe u materici.
Talozi crnog ugljenika iz zagađenja vazduha pronađeni su u čitavom ljudskom telu, uključujući u posteljicama analiziranim posle rođenja.
„Ne postoji razlog da ono odabere neki organ pre nego neki drugi“, kaže Liu, „tako da su velike šanse da ih ima svuda.“
A postoje i drugi oblici zagađenja vazduha, kao što su azotni oksidi, koji su gasovi i nisu vidljivi pod mikroskopom, ali se zna da prave štetu.
Svetska zdravstvena organizacija kaže da 99 odsto svetske populacije udiše zagađen vazduh, što dovodi do sedam miliona smrti godišnje.
Izveštaj Kraljevskog koledža lekara procenjuje da je cifra za Veliku Britaniju 30.000 smrti godišnje.
Ser Stiven Holgejt, koji je predvodio taj izveštaj, rekao je da nema sumnje da zagađen vazduh škodi našem zdravlju – „sto posto je potvrđeno, gem, set i meč“ – a najjači dokaz potiče iz oblasti koje smanjuju zagađenje vazduha i sada odmah vide koristi od toga.
Ali sada kada je zagađen vazduh „uglavnom nevidljivo“, za razliku od slavnih smogova iz prošlosti, većina nas ne shvata da ga udiše i „ne shvata da je zagađenje vazduha na dnevnoj bazi jako štetno“, kaže on.
Zagađenje vazduha je povezano sa štetom kroz čitave naše živote i kroz čitavo naše telo.
Ima mnogo načina na koje nečisti vazduh može da naškodi drugim organima u našem telu, ali smatra se da je glavni izazivanje upalnih procesa.
Upala je prirodna reakcija našeg tela na povredu i infekciju, ali ona može da utiče i na krvne sudove i da učini srčane i moždane udare verovatnijim.
Pokazalo se da inflamacija u plućima budi uspavane kancerogene ćelije, koje se potom razviju u smrtonosne tumore.
Veruje se da je oko jedan od 10 rakova pluća izazvalo zagađenje vazduha u Velikoj Britaniji.
Čak i dok su u materici, veruje se da zagađenje vazduha može čak i da utiče na to kako funkcioniše DNK bebe u razvoju tokom ključnih stadijuma razvoja.
„Postoji jedan veoma osetljiv period kad zagađenje vazduha može da izazove problem i ono to nesumnjivo i čini: mala pluća, malo srce i određeni problemi za razvojem mozga“, kaže ser Stiven.
Na drugom kraju života, izgleda da komponente zagađenja vazduha „ubrzavaju proces“ demencije, kaže on, pomažući plakovima toksičnih proteina unutar mozga.
Šta vi tu možete da uradite?
Postoji savet kako da minimizujemo našu izloženost zagađenom vazduhu – kao što su hodanje po neprometnijoj strani ulice ili udaljavanje od ivice puta da biste bili što dalje od saobraćaja.
Ovo je posebno važno za bebe u kolicima, koje su mnogo bliže visini auspuha.
Grigova studija je pokazala da je zategnuta FFP2 maska dovela do manje zagađenja vazduha u krvi, ali „mi ne kažemo da svako treba da nosi masku“, kaže Grig, dodavši da neki klinički ugroženi ljudi među kojima su oni „koji se oporavljaju od srčanog udara ili imaju hronične respiratorne bolesti“ mogu imati koristi od maske dok se nalaze u oblastima visokog zagađenja.
Ali, najteža stvar u vezi sa zagađenim vazduhom je to što vi često udišete zagađenje koje su izazvali drugi ljudi.
Nije lako naprosto živeti negde drugde ako se vaša kuća nalazi na prometnom putu.
Promene na automobilima – ne samo prodaja električnih automobila, već i standardi emisija na novijim dizel i benzinskim motorima – poboljšavaju kvalitet vazduha.
Međutim, Grig kaže: „Mislim da što više razumemo mehanizme kako ono može da izazove ove posledice, više možemo da doprinesemo pritisku na kreatore politike da smanje našu izloženost – zato što se na kraju tu krije pravi odgovor.“
Pratite nas na Fejsbuku, Tviteru, Instagramu, Jutjubu i Vajberu. Ako imate predlog teme za nas, javite se na bbcnasrpskom@bbc.co.uk
- Sarajevo najzagađenija prestonica sveta, još balkanskih gradova u vrhu
- Kako se meri zagađenje vazduha i koji nivoi su opasni za ljude
- Koji su aktivni, a koji napušteni rudnici metala u Srbiji
- Život pored termoelektrane u Tuzli: 'Ovde je normalno ako dođeš do pedesete i onda umreš'
- Požar na deponiji u Kraljevu: Da li sagorevanje otpada utiče na zdravlje
Ukoliko imate potrebu za radnom snagom nudimo vam mogućnost da na jednostavan način oglasite poziciju za posao.
Radno mesto možete oglasiti u odeljku Oglasi za posao ili jednostavno klikom na ovu poruku.
























Komentari 0
Nema komentara na izabrani dokument. Budite prvi koji će postaviti komentar.
Komentari čitalaca na objavljene vesti nisu stavovi redakcije portala 021 i predstavljaju privatno mišljenje anonimnog autora.
Redakcija 021 zadržava pravo izbora i modifikacije pristiglih komentara i nema nikakvu obavezu obrazlaganja svojih odluka.
Ukoliko je vaše mišljenje napisano bez gramatičkih i pravopisnih grešaka imaće veće šanse da bude objavljeno. Komentare pisane velikim slovima u većini slučajeva ne objavljujemo.
Pisanje komentara je ograničeno na 1.500 karaktera.
Napiši komentar